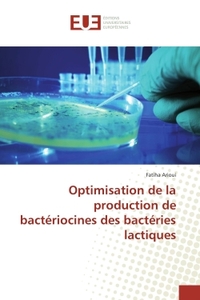
Optimisation de la production de bactériocines des bactéries lactiques

Nous utilisons des cookies pour améliorer votre expérience. Pour nous conformer à la nouvelle directive sur la vie privée, nous devons demander votre consentement à l’utilisation de ces cookies. En savoir plus.
Caractéristiques techno-fonctionnelles de la gélatine bovine
Univ Europeenne - EAN : 9786138420613
Édition papier
EAN : 9786138420613
Paru le : 1 sept. 2018
39,90 €
37,82 €
Disponible
Pour connaître votre prix et commander, identifiez-vous
Notre engagement qualité
-
Livraison gratuite
en France sans minimum
de commande -
Manquants maintenus
en commande
automatiquement -
Un interlocuteur
unique pour toutes
vos commandes -
Toutes les licences
numériques du marché
au tarif éditeur -
Assistance téléphonique
personalisée sur le
numérique -
Service client
Du Lundi au vendredi
de 9h à 18h
- EAN13 : 9786138420613
- Réf. éditeur : 1204461
- Editeur : Univ Europeenne
- Date Parution : 1 sept. 2018
- Disponibilite : Disponible
- Barème de remise : NS
- Nombre de pages : 64
- Format : H:229 mm L:152 mm E:4 mm
- Poids : 108gr
- Interdit de retour : Retour interdit
- Résumé : Les gélifiants, les stabilisants et les épaississants sont peu connu par le consommateur et pourtant ils sont omniprésents dans la plupart des aliments transformés et consommés au quotidien. Ces additifs alimentaires sont souvent obtenus à partir d'une large gamme de plantes, des microorganismes et des tissus conjonctifs d'animaux. La gélatine a depuis longtemps attirée l'attention des chercheurs comme source de protéine, stabilisant et améliorant des propriétés rhéologiques des produits alimentaires. Son utilisation est retrouvée aujourd'hui dans plusieurs domaines d'intérêt. C'est dans l'intention d'améliorer la consistance et la qualité organoleptique ainsi que les aptitudes à la conservation des laits fermentés (type yaourt étuvé) qu'on s'est proposé d'introduire dans la préparation comme ingrédient naturel la gélatine d'osséine. La gélatine est extraite par hydrolyse acide du collagène des os de bovin.Les propriétés techno-fonctionnelles de la gélatine extraite sont étudiées. Des laits fermentés sont ensuite préparés à différents taux d'incorporation de cet additif afin d'étudier l'effet de la gélatine sur la qualité des yaourts pendant la fermentation et la conservation.
- Biographie : Doctorante (spécialité technologie alimentaire)l'université Abdelhamid Ibn Badis, Algérie. Titulaire d'un diplôme d'ingénieur d'état option sciences alimentaires. et d'un diplôme de master option sciences des aliments. membre d'un projet de recherche: optimisation de la production de fromage traditionnel (jben). Enseignante à l'université de Chlef